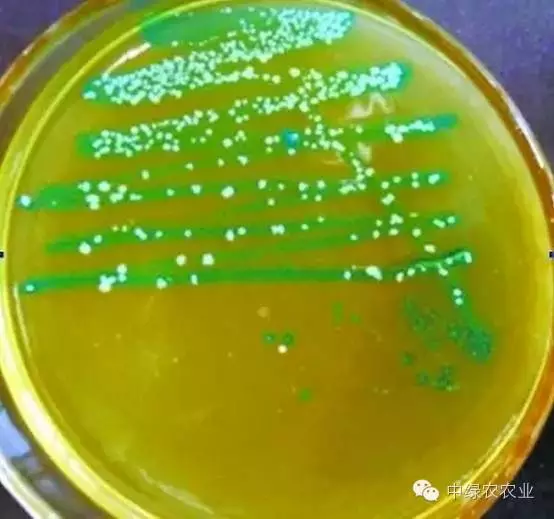
冰箱里隐藏的细菌杀伤力极大,必知!

冰箱微生物

冰箱里藏着万种细菌?
图片尺寸800x800
冰箱异味细菌滋生,放一只棒棒进去,30天持久保鲜杀菌
图片尺寸464x445
临床微生物科 健康科普 炎炎夏日来临,冰箱成为生活中的好帮手.
图片尺寸500x268
别总惦记着秋天的第一杯奶茶,有空把冰箱洗洗
图片尺寸640x575
同时,冰箱里长期存放营养丰富的食物,自然也会成为各种微生物的聚集地
图片尺寸640x468
冰箱不仅是食物的储藏地也是细菌的藏身窝点
图片尺寸1140x777
美的冰箱首发中国家庭冰箱微生物数据库引领行业除菌科技升级
图片尺寸829x462
有官方栏目曾邀请专家专门采集了普通家庭冰箱内部微生物样本,将样本
图片尺寸660x423
冰箱中的微生物ppt
图片尺寸1080x810
冰箱冷冻室使用指南为了避免误食感染了微生物的食物危害健康,冰箱
图片尺寸640x360
冰箱——一个被忽视的微生物活动"乐园"
图片尺寸593x368
冰箱里隐藏的细菌杀伤力极大,必知!
图片尺寸720x675
冰箱中的微生物
图片尺寸920x690
看了这些,还认为冰箱是"保险箱"吗?|细菌|冷冻室|微生物_网易订阅
图片尺寸452x306
馒头上的霉菌长得非常好,堪比实验室培养基上培养的微生物
图片尺寸640x360
能存放多久?_温度_微生物_冰箱
图片尺寸640x427
馒头上的霉菌长得非常好,堪比实验室培养基上培养的微生物
图片尺寸640x360
冰箱里总有一股异味?放颗"蛋"就能轻松搞定!
图片尺寸640x261
漫画冰箱里竟然能藏20多种致病微生物尤其这几种太吓人了
图片尺寸726x1038
冰箱里竟然能藏20多种致病微生物尤其这几种太吓人了
图片尺寸699x1000